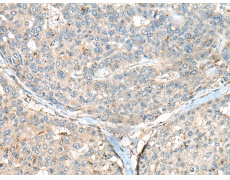
一抗

中文名稱:兔抗CASR多克隆抗體
英文名稱: Anti-CASR rabbit polyclonal antibody
別 名: calcium sensing receptor; CAR; FHH; FIH; HHC; EIG8; HHC1; NSHPT; PCAR1; GPRC2A; HYPOC1
相關(guān)類別: 一抗
儲 存: 冷凍(-20℃)
宿 主: Rabbit
抗 原: CASR
反應(yīng)種屬: Human
標(biāo) 記 物: Unconjugate
克隆類型: rabbit polyclonal
技術(shù)規(guī)格
|
Background: |
The protein encoded by this gene is a G protein-coupled receptor that is expressed in the parathyroid hormone (PTH)-producing chief cells of the parathyroid gland, and the cells lining the kidney tubule. It senses small changes in circulating calcium concentration and couples this information to intracellular signaling pathways that modify PTH secretion or renal cation handling, thus this protein plays an essential role in maintaining mineral ion homeostasis. Mutations in this gene cause familial hypocalciuric hypercalcemia, familial, isolated hypoparathyroidism, and neonatal severe primary hyperparathyroidism. |
|
Applications: |
ELISA, IHC |
|
Name of antibody: |
CASR |
|
Immunogen: |
Fusion protein of human CASR |
|
Full name: |
calcium sensing receptor |
|
Synonyms: |
CAR; FHH; FIH; HHC; EIG8; HHC1; NSHPT; PCAR1; GPRC2A; HYPOC1 |
|
SwissProt: |
P41180 |
|
ELISA Recommended dilution: |
5000-10000 |
|
IHC positive control: |
Human gastric cancer and Human liver cancer |
|
IHC Recommend dilution: |
50-300 |


 購物車
購物車 幫助
幫助
 021-54845833/15800441009
021-54845833/15800441009